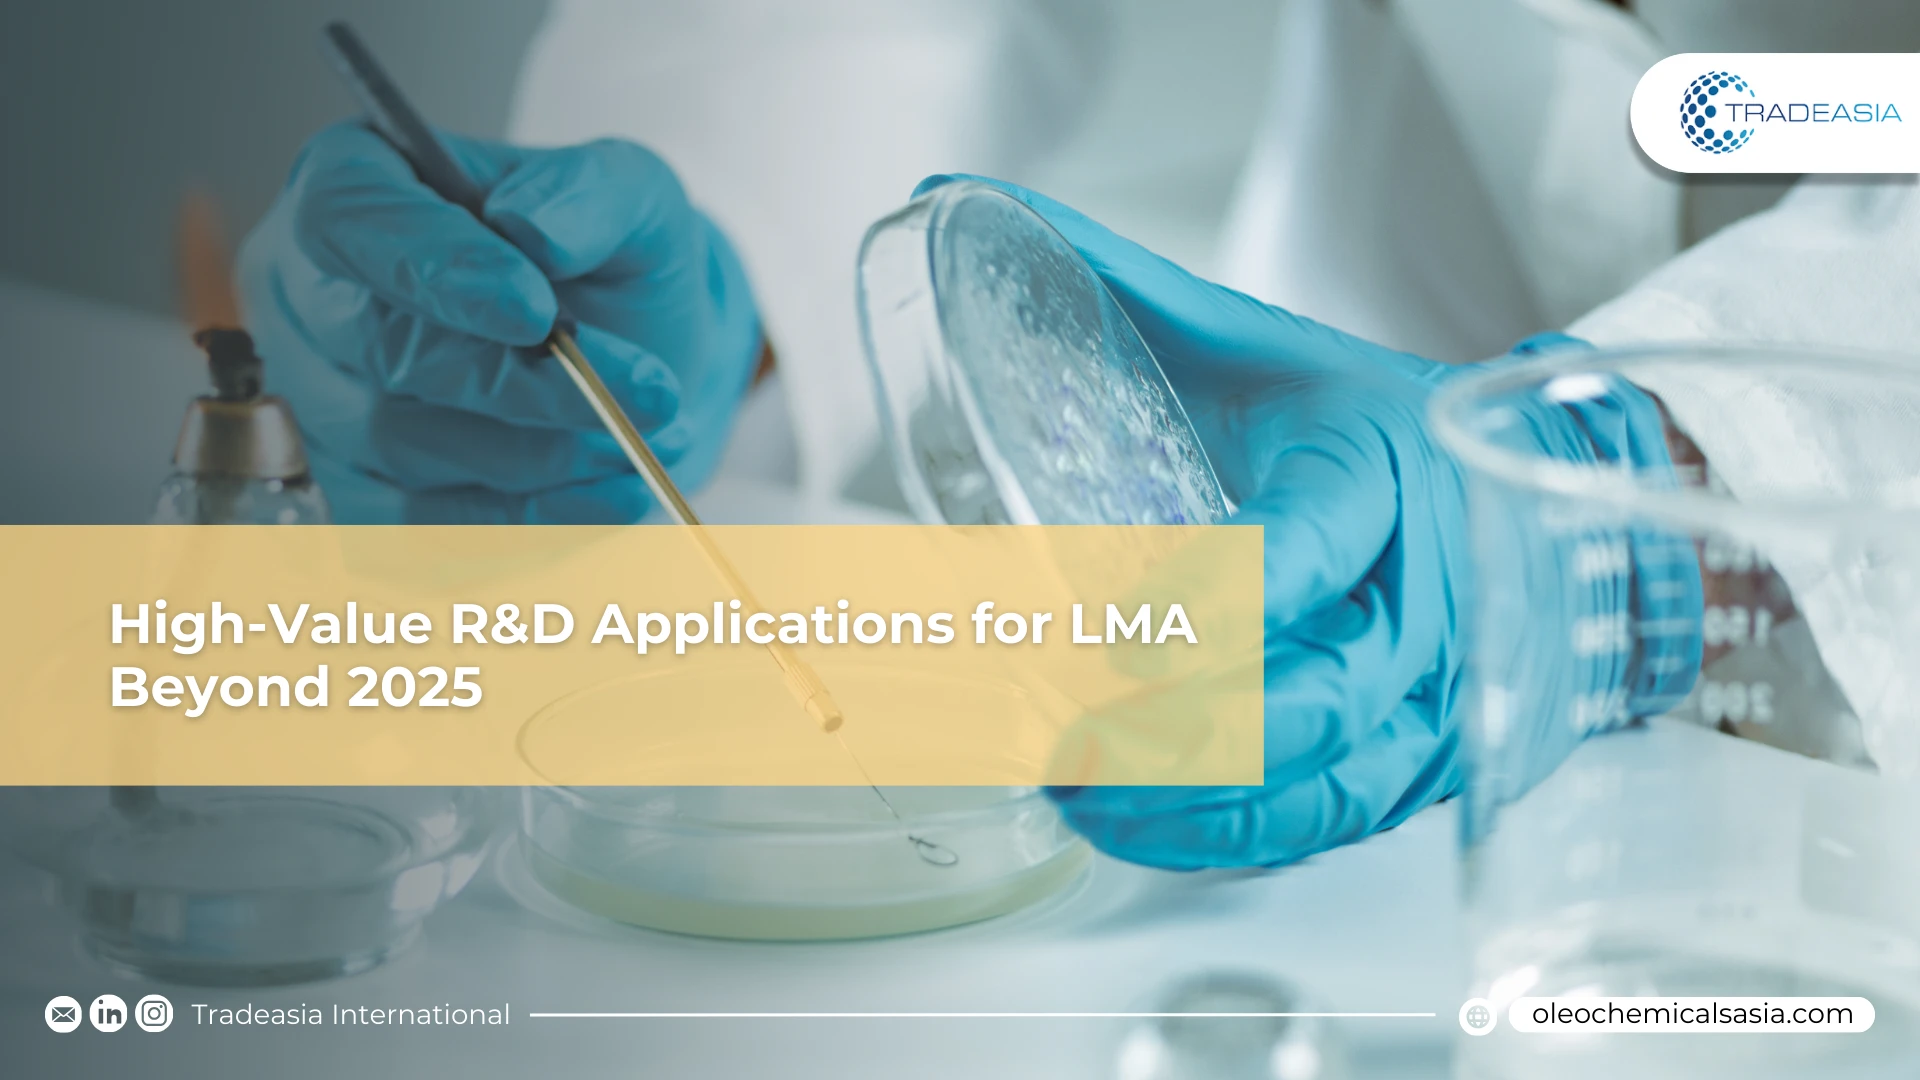

3 Matching result for "Pharmaceutical Excipients "
Filter by :
Sort by :

Market Insight
From Additive to Active: R&D Unlocking High-Value DMG Applications
See how R&D is elevating DMG from an additive to a high-value active ingredient. Discover its new role in pharmaceuticals, improving drug bioavailability by 40%, and its potential in the 12% CAGR nutraceutical market.
16 October 2025

Insight
A Strategic Pivot: Cetyl Stearyl Alcohol's High-Value Pharmaceutical Future
Explore the pharmaceutical future of cetyl stearyl alcohol in 2025. Learn how high-purity excipients and R&D innovations are driving growth in controlled-release drug delivery.
29 September 2025
Insight
High-Value R&D Applications for LMA Beyond 2025
Uncover the future of LMA. Cutting-edge R&D is unlocking its potential in high-value markets like pharmaceuticals, agriculture, and high-performance bio lubricants.
16 September 2025